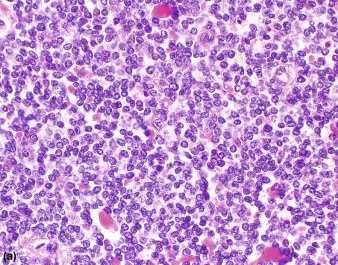
Ewing sarcoma histology: small round blue cells

Basics - Blue Cell Tumour
- Small round blue cell tumour (SRBCT) of bone and soft tissue.
- Origin: Believed to be of neural crest cell / neuroectodermal origin.
- Microscopy:
- Sheets of uniform, small cells with round nuclei and scant, clear cytoplasm.
- Homer-Wright pseudorosettes (cells around a fibrillary meshwork) may be seen.
- Cytoplasm is PAS-positive due to glycogen, which is diastase-sensitive.
- IHC Marker: CD99 (MIC2) is the most sensitive marker.
⭐ Genetic Hallmark: Translocation t(11;22)(q24;q12), resulting in the EWS-FLI1 fusion gene.
Pathogenesis - Translocation Tango
- Primary Driver: Specific chromosomal translocations.
- Classic Translocation: t(11;22)(q24;q12) is the hallmark, found in ~85% of cases.
- Fuses the EWSR1 gene on chromosome 22 with the FLI1 gene on chromosome 11.
- Creates the EWSR1-FLI1 fusion oncogene.
- Fusion Protein: The resulting chimeric protein acts as an aberrant transcription factor, driving oncogenesis.
- 📌 Mnemonic: Think of basketballer Patrick Ewing (jersey #33): 11 + 22 = 33.
⭐ The EWSR1-FLI1 fusion is the most common type. Other partners for EWSR1 exist (e.g., ERG), but are less frequent.
chromosomal translocation diagram)
Diagnosis - Onion Skin & Codman
- X-ray Findings: The initial imaging modality.
- Location: Most commonly affects the diaphysis of long bones (femur, tibia, humerus) and the pelvis.
- Appearance: Poorly-defined, lytic lesion with a permeative or "moth-eaten" pattern of bone destruction.
- Periosteal Reaction: Key diagnostic signs.
- "Onion skin" appearance: A lamellated, layered reaction.
- Codman triangle: A triangular area of new subperiosteal bone.
- A "sunburst" or "hair-on-end" pattern can also occur.
⭐ Exam Favourite: The classic description is a destructive lesion in the diaphysis of a long bone with an "onion skin" periosteal reaction.

Management - Chemo Sandwich
- Overall Strategy: A multi-modal approach combining chemotherapy and local control measures, structured like a sandwich.
-
Neoadjuvant (Induction) Chemotherapy:
- Pre-operative treatment to shrink the primary tumor.
- Regimen: VDC/IE (Vincristine, Doxorubicin, Cyclophosphamide alternating with Ifosfamide, Etoposide).
-
Local Control:
- Surgery: Wide local excision / limb salvage is preferred.
- Radiotherapy: For unresectable tumors or positive surgical margins.
-
Adjuvant Chemotherapy:
- Post-local control to eradicate micrometastases.
⭐ The VDC/IE regimen, administered over 9-12 months, is the standard of care and a major factor in improved survival rates for Ewing sarcoma.
High‑Yield Points - ⚡ Biggest Takeaways
- Second most common primary malignant bone tumor in children, after osteosarcoma.
- A small round blue cell tumor of neuroectodermal origin.
- Characteristic translocation is t(11;22), resulting in the EWS-FLI1 fusion gene.
- Most commonly involves the diaphysis of long bones (like the femur) and the pelvis.
- X-ray findings include lytic lesions with an "onion skin" periosteal reaction.
- Histology may show Homer-Wright rosettes.
Unlock the full lesson and continue reading
Signup to continue reading this lesson and unlimited access questions, flashcards, AI notes, and more